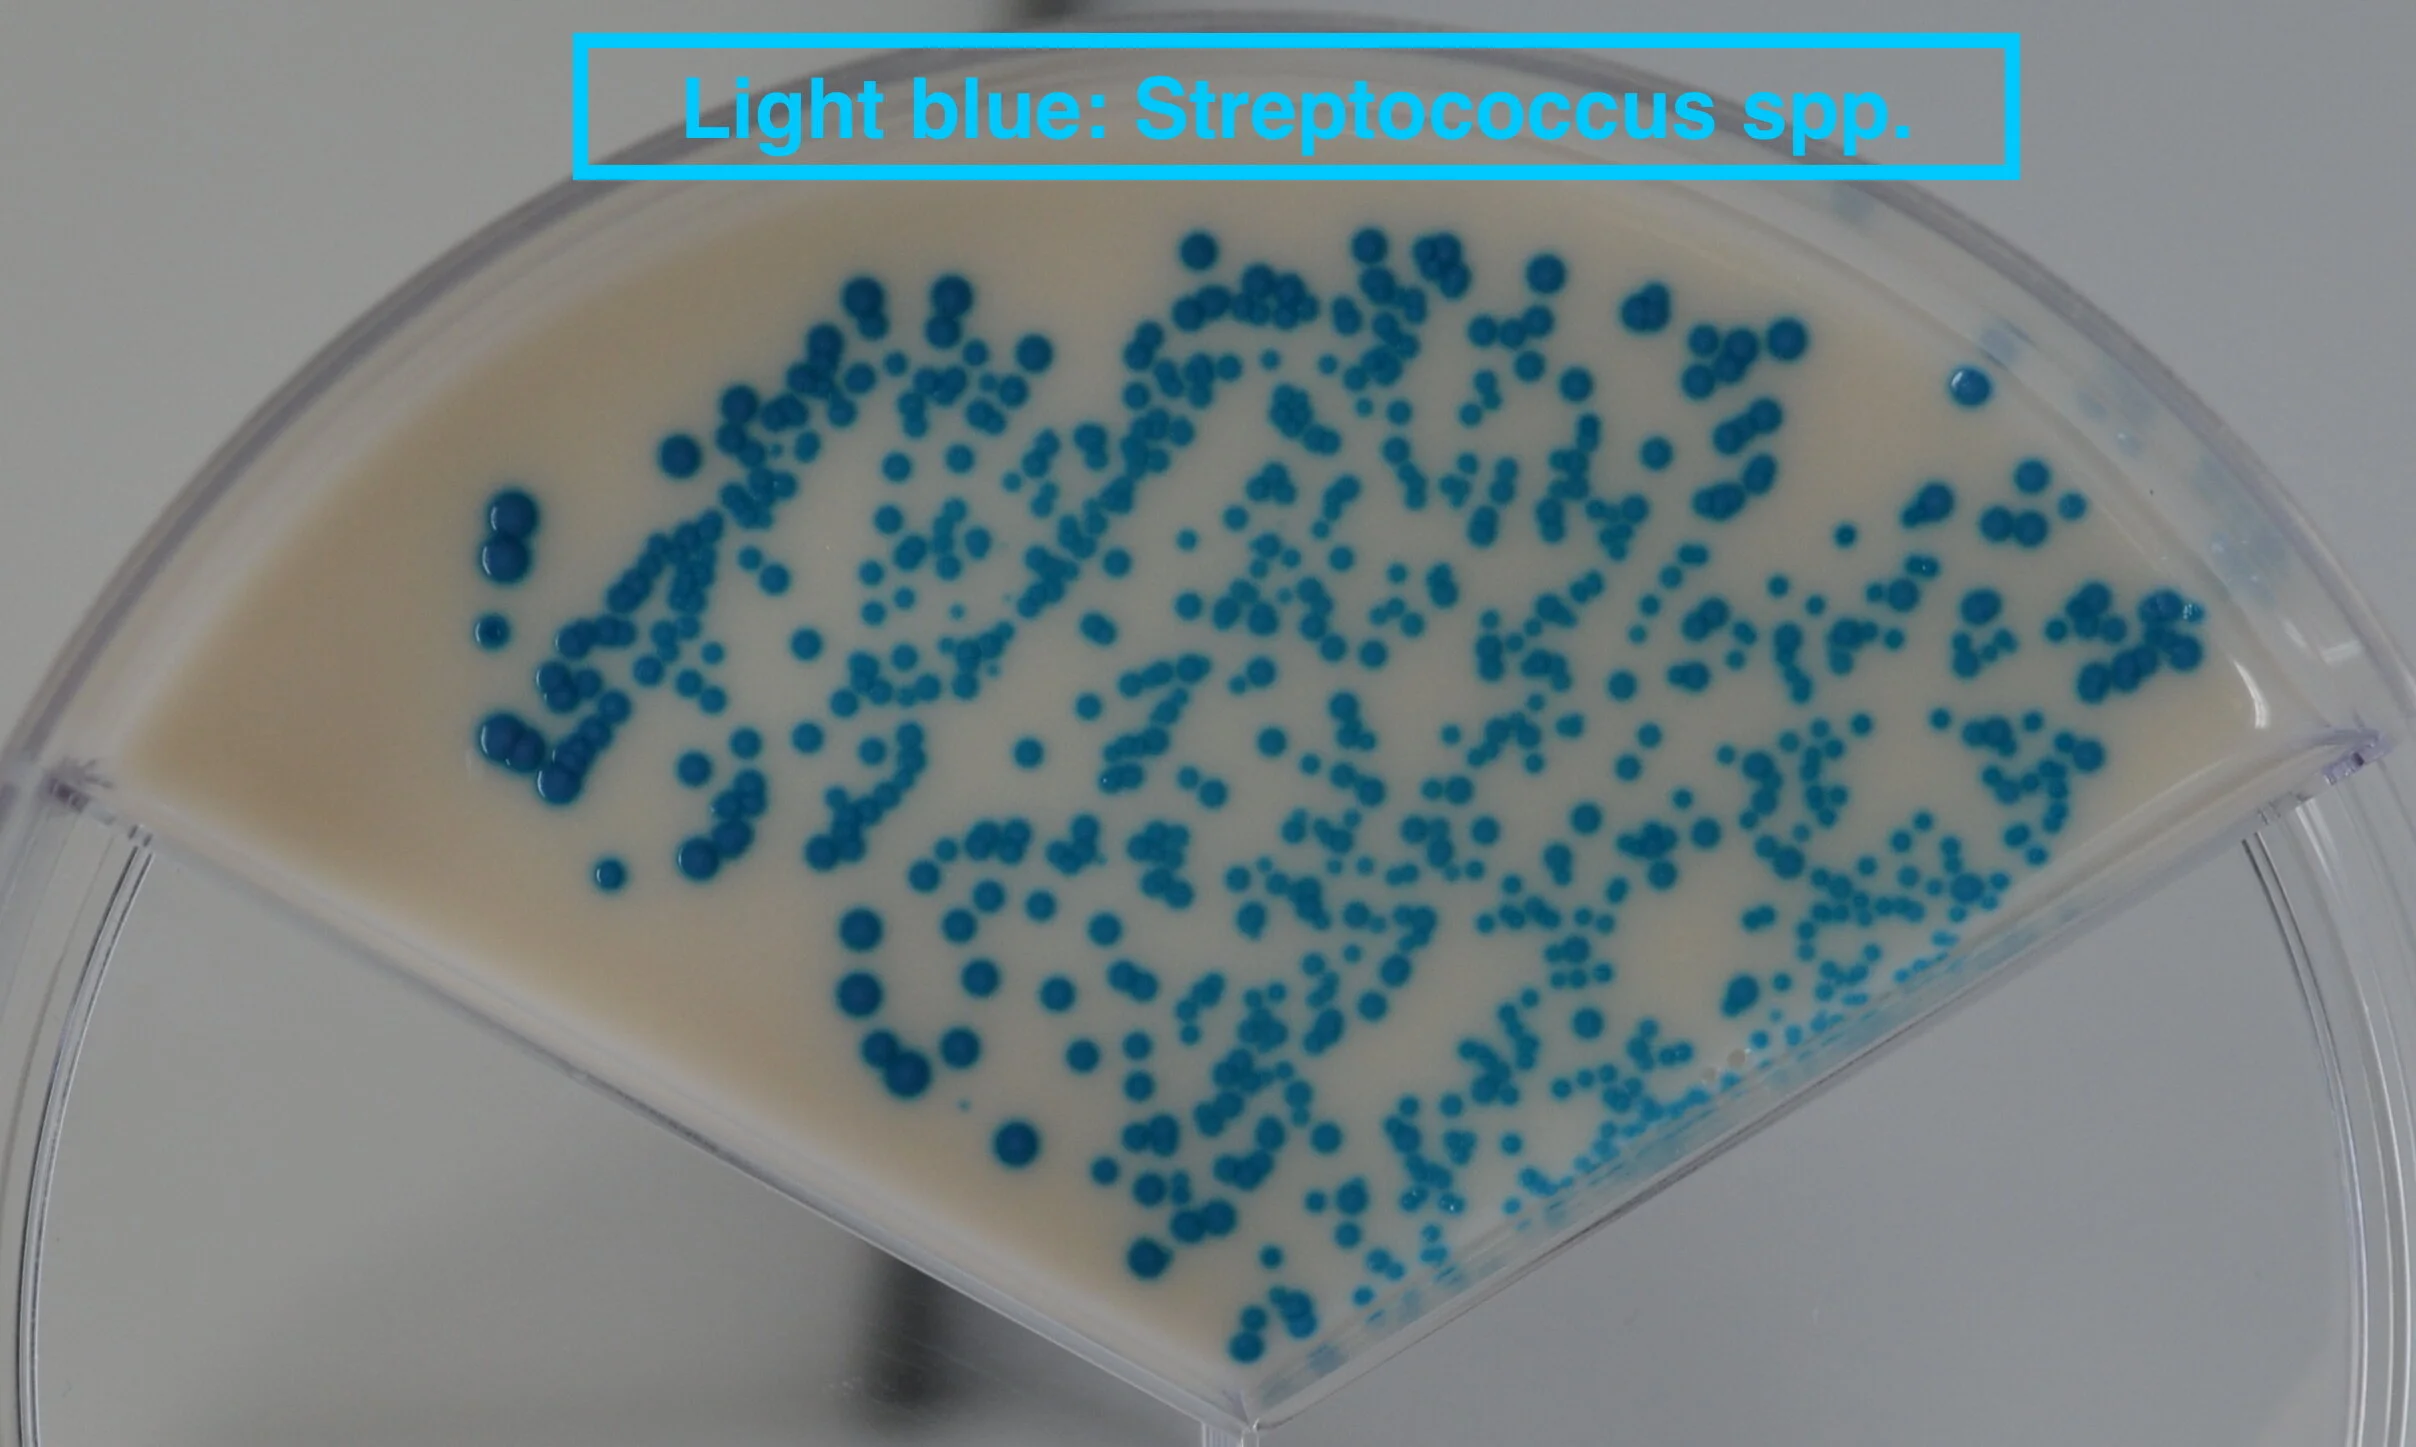
Streptococcus spp..JPG

AccuMast Mastitis Detection Plates

AccuMast Mastitis Detection Plates
AccuMast Detection Plates offer a fast, easy and accurate way to test for mastitis in milk.
Producing clear, visual lab results in just 16 hours, AccuMast enables farmers to pinpoint the cause of mastitis on the farm and decide on the best course of treatment.
Use AccuMast Mastitis Detection Plates to test for
All treatable mastitis pathogens in raw milk.
Why Choose AccuMast Mastitis Detection Plates?
They provide a user-friendly, on-farm testing solution to detect specific mastitis causes
AccuMast is the only test that correctly identifies Staphylococcus aureus – the most dangerous of all common staphylococcus bacteria
The test provides colour-coded results that are easy to read and identify
With AccuMast there are far fewer contaminated samples than with traditional lab cultures
It enables you to test for multiple varieties of mastitis pathogens on a single plate.
How do AccuMast Detection Plates Work?
AccuMast Mastitis Detection Plates are designed for easy application and interpretation.
These test kits come in packs of four petri dishes, split into three sections. Each section detects three different categories of bacteria:
Gram negative
Streptococcus
Staphylococcus.
First, you collect your sample in a sterile container. Turn the container upside down to mix the sample thoroughly. Dip your sterile swab into the container.
Apply milk samples directly onto each section of the plate with the swab. Then incubate the plate for 16 hours at 37°C.
After incubation, to identify the cause of clinical mastitis, you examine the three sections of the culture plate to see what colour of culture is growing on the plate.
There are clear instructions to advise you on what each colour result means.
Once you have this information, you can make an informed decision about mastitis treatment.
On-farm Mastitis Testing
The user-friendly design of AccuMast Mastitis Detection Plates makes them ideal for on-farm testing.
Mastitis is a costly disease in cattle. It can have a devastating impact on milk yields.
With AccuMast tests, you have an efficient tool for use on the farm that will help you protect your herd, your produce and your livelihood from the damaging effects of mastitis.
For more information, please contact us.
